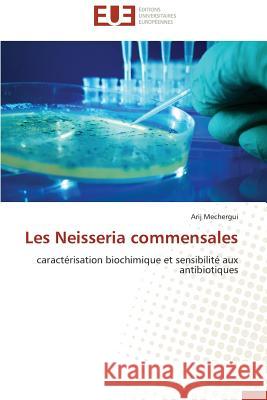
Les Neisseria Commensales Mechergui-A 9786131581069 Editions Universitaires Europeennes

» książki » Science - Life Sciences - Microbiology
 |
Molecular Identification of Landfills Bacterial Strains
ISBN: 9783845434155 / Angielski / Miękka / 56 str. Termin realizacji zamówienia: ok. 5-8 dni roboczych. Landfills are the important areas in any country. They have the high microbial populations that perform very important functions like, Methanogenesis, conversion of biological polymers into sugars, degradation of different pesticides and herbicides etc. Identification of these microbes is very beneficial. This book shows that new bacterial species has been identified from the landfills of District Gujrat, Pakistan. Species identification would make possible to get valuable functions from these bacterial strains
Landfills are the important areas in any country. They have the high microbial populations that perform very important functions like, Methanogenesis,...
|
cena:
160,58 |
 |
Interacciones Microbianas En La Rizosfera
ISBN: 9783847369783 / Hiszpański / Miękka / 76 str. Termin realizacji zamówienia: ok. 5-8 dni roboczych. Las bacterias presentes en la rizosfera se encuentran interactuando con numerosos microorganismos (competidores y depredadores), lo cual favorece la evolucion de mecanismos de competencia y resistencia a la depredacion, como la liberacion de metabolitos bioactivos. Pseudomonas fluorescens CHA0 es una bacteria conocida por ser capaz de producir una amplia variedad de estos metabolitos entre los que podemos mencionar el 2,4-diacetilfloroglucinol (DAPG), la pioluteorina (PLT), el cianuro de hidrogeno (HCN), asi como los acidos gluconico y 2-cetogluconico, producidos por la via de oxidacion...
Las bacterias presentes en la rizosfera se encuentran interactuando con numerosos microorganismos (competidores y depredadores), lo cual favorece la e...
|
cena:
160,58 |
|
Les Neisseria Commensales
ISBN: 9786131581069 / Francuski / Miękka / 64 str. Termin realizacji zamówienia: ok. 5-8 dni roboczych. Ce document constitue une synthese inedite s'interessant aux Neisseria commensales. Il presente une etude retrospective de 34 souches de Neisseria commensales isolees chez des patients immunodeprimes, hospitalises au Centre National de Greffe de Moelle Osseuse de Tunis. Une predominance de N. subflava var. perflava et des taux eleves de sensibilite diminuee aux β-lactamines, de resistance a la rifampicine et au chloramphenicol ont ete trouves avec une diversite genetique importante du gene penA codant pour la proteine de liaison aux penicillines. Cet ouvrage constitue une bonne base pour...
Ce document constitue une synthese inedite s'interessant aux Neisseria commensales. Il presente une etude retrospective de 34 souches de Neisseria com...
|
cena:
160,58 |
 |
Mécanismes d'Invasion Cellulaire de Listeria Monocytogenes
ISBN: 9786131583612 / Francuski / Miękka / 56 str. Termin realizacji zamówienia: ok. 5-8 dni roboczych. Listeria monocytogenes, bactA(c)rie A Gram positif capable de survivre dans l'environnement comme saprophyte, est responsable chez l'homme de la listeriose, une maladie plA(c)iotropique d'origine alimentaire caractA(c)risA(c)e par des gastroentA(c)rites fA(c)briles et des septicA(c)mies graves chez les individus immunodA(c)primA(c)s, des avortements chez la femme enceinte ou des mA(c)ningo-encA(c)phalites chez le nouveau-nA(c). La patho-physiologie de la listeriose est liA(c)e intimement A la capacitA(c) de L. monocytogenes d'envahir l'espace intracellulaire des cellules de mammifA]re, une...
Listeria monocytogenes, bactA(c)rie A Gram positif capable de survivre dans l'environnement comme saprophyte, est responsable chez l'homme de la liste...
|
cena:
160,58 |
 |
Analiza Mikroflory Surowcow Pochodzenia Ro Linnego
ISBN: 9783639890020 / Polski / Miękka / 60 str. Termin realizacji zamówienia: ok. 5-8 dni roboczych. Rodzima mikroflora surowcow roślinnych korzystnie wplywa na przebieg wielu procesow produkcyjnych. Jednakże surowce roślinne mogą byc zanieczyszczane przez drobnoustroje pochodzące z gleby, powietrza oraz wody. Szczegolnie niebezpieczne są bakterie chorobotworcze dla ludzi, ktore wywolują groźne choroby. Ponadto duże ryzyko związane jest z rozwojem grzybow pleśniowych na surowcach roślinnych. Mają one zdolnośc wytwarzania mykotoksyn o silnym dzialaniu kancerogennym. Znajomośc mikroflory surowcow roślinnych oraz...
Rodzima mikroflora surowcow roślinnych korzystnie wplywa na przebieg wielu procesow produkcyjnych. Jednakże surowce roślinne mogą ...
|
cena:
160,58 |
 |
Intestinal Parasites in HIV Positive and Art Naive Individuals
ISBN: 9783659536281 / Angielski / Miękka / 72 str. Termin realizacji zamówienia: ok. 5-8 dni roboczych. The human Immune responses are directed to eliminate infectious pathogens from the host body. Th1 CD4 cells are involved in the destruction and removal of intracellular pathogens while Th2 CD4 cells are responsible for ejection of extracellular parasites. Since Th1 and Th2 immune cells are cross regulatory molecules, intestinal (extracellular) parasites, initiate the type two immune responses in which more CD4 Th2 cells are produced and the host immune response become activated chronically. In Th2 directed chronic immune activation, Th1 immune cells become down regulated by a strong...
The human Immune responses are directed to eliminate infectious pathogens from the host body. Th1 CD4 cells are involved in the destruction and remova...
|
cena:
160,58 |
 |
Tuberculosis in Cattle and Buffalo in Islamabad, Pakistan
ISBN: 9783659514562 / Angielski / Miękka / 76 str. Termin realizacji zamówienia: ok. 5-8 dni roboczych. Prevalence of tuberculosis in Islamabad area is low and most of the herds were free from tuberculosis. Further, animals giving positive reaction to tuberculin were apparently healthy and their milk was also culture negative. These animals might have been in initial stages of the disease. Tuberculin test provided baseline information about the herd status; however, advanced techniques should be used to confirm the results
Prevalence of tuberculosis in Islamabad area is low and most of the herds were free from tuberculosis. Further, animals giving positive reaction to tu...
|
cena:
160,58 |
 |
The survey of microbiological contamination in pitcher cheese
ISBN: 9783659554513 / Angielski / Miękka / 64 str. Termin realizacji zamówienia: ok. 5-8 dni roboczych. Summary: We know that milk has been known as a suitable peripheral culture for growing different kinds of microorganisms such as spices of salmonella, staphylococcus, E.Coli, coliform and may cause contamination in producing cheese . The purpose of my study is investigation the rate of contamination in pitcher cheese with mentioned microbes in West Azarbayjan Iran. From 42 samples of cheese 4 samples showed contaminating by positive staphylococcus aureus coagulase, 21 samples showed contaminating by coliform and 17 samples showed E.Coli . 7 samples showed contaminating by streptococcus...
Summary: We know that milk has been known as a suitable peripheral culture for growing different kinds of microorganisms such as spices of salmonella,...
|
cena:
160,58 |
 |
Seleção de micro-organismos fermentadores de xilose em etanol
ISBN: 9783639616392 / Portugalski / Miękka / 80 str. Termin realizacji zamówienia: ok. 5-8 dni roboczych. A utilizacao dos residuos da agroindustria para a criacao de novos produtos com valor agregado e uma ferramenta muito importante que vem merecendo destaque no pais e no mundo. O Brasil e considerado um dos paises que mais geram residuos, desta forma a transformacao destes compostos em novos produtos e imprescindivel ja que contribui para a preservacao ambiental, promovendo a adequada disposicao dos mesmos no ambiente. Neste contexto, as industrias vinicolas tem destaque, ja que o subproduto gerado por elas e de lenta decomposicao e acarreta em poluicao do meio ambiente. A casca e a semente da...
A utilizacao dos residuos da agroindustria para a criacao de novos produtos com valor agregado e uma ferramenta muito importante que vem merecendo des...
|
cena:
160,58 |
 |
Diversidad de hongos marinos asociados a Rhizophora mangle
ISBN: 9783659003165 / Hiszpański / Miękka / 68 str. Termin realizacji zamówienia: ok. 5-8 dni roboczych. Los hongos marinos son un grupo ecologico y comprenden un estimado de 1500 especies, incluyendo las que forman liquenes. La diversidad fungica esta poco estudiada a nivel global de ellos mas de 287 se encuentran colonizando sustratos del manglar. En dicho ecosistema desarrollan un papel importante en la degradacion de la materia organica y reciclaje de los nutrientes. En Cuba, hasta el momento solamente 44 especies han sido descritas. En este estudio se caracterizo cuatro manglares del litoral sur de la Reserva de la Biosfera Cienaga de Zapata, Cuba, empleadose el metodo de paneles sumergidos...
Los hongos marinos son un grupo ecologico y comprenden un estimado de 1500 especies, incluyendo las que forman liquenes. La diversidad fungica esta po...
|
cena:
160,58 |
 |
Biodegradation of a field pesticide
ISBN: 9783659556890 / Angielski / Miękka / 72 str. Termin realizacji zamówienia: ok. 5-8 dni roboczych. Elimination of pollutants from contaminated sites using microorganisms is an economical alternative to chemical technology. A bacterium capable of utilizing Parathion as sole carbon and energy source isolated from agriculture effluent using selective enrichment on MS media containing Parathion, a commonly used insecticide. The strain was identified as belonging to the genus Cupriavidus based on a phylogram constructed. The experiment was studied under submerged culture in selective broth at varied interval of time in view of dry weight of bacterial biomass, further emphasizing the...
Elimination of pollutants from contaminated sites using microorganisms is an economical alternative to chemical technology. A bacterium capable of uti...
|
cena:
160,58 |
 |
Temperature Treatment
ISBN: 9783659549083 / Angielski / Miękka / 56 str. Termin realizacji zamówienia: ok. 5-8 dni roboczych. Vibrio parahaemolyticus (Vp) and Vibrio vulnificus (Vv) are halophilic bacteria naturally occurring in estuarine environments that may concentrate in filter feeding shellfish. Consumption of raw or under-cooked seafood contaminated with Vp or Vv may lead to the development of acute gastroenteritis or fatal septicemia in at-risk individuals, respectively. This book encompassed two separate but related projects: evaluation of a low temperature pasteurization (LTP) technique for the reduction of Vp and Vv in commercial quantities of shucked oysters (SO) and the investigation of the efficacy of a...
Vibrio parahaemolyticus (Vp) and Vibrio vulnificus (Vv) are halophilic bacteria naturally occurring in estuarine environments that may concentrate in ...
|
cena:
160,58 |
 |
Study on Mycobactins from Different Mycobacterial Origin
ISBN: 9783659565830 / Angielski / Miękka / 68 str. Termin realizacji zamówienia: ok. 5-8 dni roboczych. To meet the demand of iron, an essential factor for growth, mycobacteria synthesize cell associated compounds called mycobactins to grow in iron restricted conditions. Mycobacterium avium subsp paratuberculosis is unable to synthesize required amount of mycobactin and require exogenous mycobactin. The mycobactins were extracted from various mycobacterial species can be used as a growth promoter of Mycobacterium avium subsp paratuberculosis. This book provide detail review on paratuberculosis and mycobactin production.
To meet the demand of iron, an essential factor for growth, mycobacteria synthesize cell associated compounds called mycobactins to grow in iron restr...
|
cena:
160,58 |
 |
Occurance & Abundance of Arbuscular-Mycorrhizal Fungal Spores in Soil
ISBN: 9783659175817 / Angielski / Miękka / 72 str. Termin realizacji zamówienia: ok. 5-8 dni roboczych. This book will give a complete idea about the occurrence and abundance of ARBUSCULAR MYCORRHIZAL fungal spores in soil of forest college and research institute. It will also give idea of preparation staining of root nodules. Methodology given in chapter three will be helpful for the students and research scholars for their works. The working principles of latest microscopes with working stations
This book will give a complete idea about the occurrence and abundance of ARBUSCULAR MYCORRHIZAL fungal spores in soil of forest college and research ...
|
cena:
160,58 |
 |
Medio de cultivo libre de suero para Giardia lamblia
ISBN: 9783659013256 / Hiszpański / Miękka / 80 str. Termin realizacji zamówienia: ok. 5-8 dni roboczych. Giardia lamblia produce desnutricion, mala absorcion de nutrientes y hasta puede llegar a causar la muerte. El medio de cultivo para G. lamblia es el TYI-S-33, pero este debe ser suplementado con suero y bilis bovina; sin embargo se ha reportado que el suero inhibe actividades biologicas importantes para su virulencia. Por ello, nos propusimos sustituir el suero y bilis bovina para el crecimiento axenico in vitro de G. lamblia.
Giardia lamblia produce desnutricion, mala absorcion de nutrientes y hasta puede llegar a causar la muerte. El medio de cultivo para G. lamblia es el ...
|
cena:
160,58 |
 |
Sewage Water Analysis
ISBN: 9783659573972 / Angielski / Miękka / 56 str. Termin realizacji zamówienia: ok. 5-8 dni roboczych. This book reveals the assessment of physical parameters like color, solid, pH & microbial parameters like total Coliform and seacal coliform . It gives various methods for analysis of sewage water and how we prevent sewage water to mix with pure water. It concerned on the pollution control and the protection of the environmental quality. Monitoring of aqueous sample by various parameters from different site of sewage treatment plat to assess, monitor and to focus on the site which are main source responsible for the water pollution.
This book reveals the assessment of physical parameters like color, solid, pH & microbial parameters like total Coliform and seacal coliform . It give...
|
cena:
160,58 |
 |
Extraction and Quantification of Nucleic Acids and Proteins
ISBN: 9783659578083 / Angielski / Miękka / 56 str. Termin realizacji zamówienia: ok. 5-8 dni roboczych. The present study was conducted to explain various techniques for the extraction and quantification of nucleic acids and proteins from plant materials. Plant samples were analysed in the laboratory for the extraction of Deoxyribonucleic acid (DNA) and Ribonucleic acid (RNA) using conventional methods and then quantification was done using spectrophotometer. Extraction and quantification of proteins was also done using conventional methods.
The present study was conducted to explain various techniques for the extraction and quantification of nucleic acids and proteins from plant materials...
|
cena:
160,58 |
 |
Microbial Biofilms of Listeria Monocytogenes
ISBN: 9783659578793 / Angielski / Miękka / 68 str. Termin realizacji zamówienia: ok. 5-8 dni roboczych. The presence of biofilm aroused increasing interest in the food business operators in what can be the cause of health problems, as well as of economic damage. The periodic detachment of bacterial cells from the biofilm, in fact, is a possible source of contamination of work environments, and then the food by both spoilage germs and pathogens. Listeria monocytogenes, a ubiquitous germ, frequently isolated from processing environments and conveyed from foods of both animal and vegetable again. L. monocytogenes, once entry within an establishment is difficult to eradicate the remarkable ability...
The presence of biofilm aroused increasing interest in the food business operators in what can be the cause of health problems, as well as of economic...
|
cena:
160,58 |
 |
Mycoplasma Genitalium Role in Infertility, Pid, Cervicitis and Boh
ISBN: 9783659584602 / Angielski / Miękka / 84 str. Termin realizacji zamówienia: ok. 5-8 dni roboczych. Mycoplasma genitalium is an emerging sexually transmitted infection worldwide. It is a well established pathogen in humans. However, investigations into the causal relationships of M. genitalium infections and woman reproductive health problems have been hindered either due to non suspicion by the clinicians or by lack of appropriate laboratory setup for its diagnosis in developing countries. A known pathogen in men, though its role in women reproductive health needs to be explored. Being a fastidious organism, it is difficult to culture and detect. With the advent of good molecular...
Mycoplasma genitalium is an emerging sexually transmitted infection worldwide. It is a well established pathogen in humans. However, investigations in...
|
cena:
160,58 |
 |
Detección de coliformes totales en quesos frescos en Mexicali, B.C.
ISBN: 9783659027413 / Hiszpański / Miękka / 52 str. Termin realizacji zamówienia: ok. 5-8 dni roboczych. La produccion de queso fresco en Mexicali es a partir de leche no pasteurizada lo cual trae como consecuencia brotes de enfermedades transmitidas por alimentos. Es por eso que el objetivo de este trabajo fue diagnosticar la presencia-ausencia de Escherichia coli y coliformes totales, mediante la implementacion de la prueba rapida DBC-E. coli en muestras de quesos frescos elaborados artesanalmente en Mexicali, Baja California."
La produccion de queso fresco en Mexicali es a partir de leche no pasteurizada lo cual trae como consecuencia brotes de enfermedades transmitidas por ...
|
cena:
160,58 |













